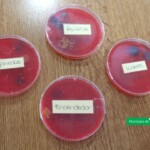
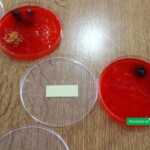

¡Alerta! la ANMAT solicita el retiro de un medicamento
[02-09-2021] El Área de Bromatología, Ambiente y Zoonosis alerta a los comercios y población en general que la Administración Nacional de Medicamentos, Alimentos y Tecnología Médica informa que la firma CRAVERI SAIC ha iniciado el retiro del mercado del producto NORFLOXACINA luego de detectarse que el lote no cumple con el ensayo de disolución.
Según se indica la prohibición, la ANMAT se trata de un agente antibacteriano utilizado en infecciones del tracto urinario, infecciones prostáticas, uretritis gonocóccica y enterocolitis bacteriana denominado NORFLOXACINA CRAVERI / NORFLOXACINA 400 mg – Comprimidos recubiertos - Envase por 10 y por 20 unidades – Certificado N° 41613 - Lote A904, vencimiento 31/03/22
Por lo antes establecido, se recomienda a quienes hayan adquirido el producto mencionado o lo tenga en su poder, se abstenga de usarlo y realizar la denuncia pertinente en el caso de encontrarlos a la venta en algún comercio para proceder a su respectivo decomiso.
¡Alerta! la ANMAT prohibió una fragancia infantil
[01-09-2021] El Área de Bromatología, Ambiente y Zoonosis alerta a los comercios y población en general que la Administración Nacional de Medicamentos, Alimentos y Tecnología Médica prohibió una fragancia cosmética infantil.
Según se indica la prohibición, la ANMAT ha ordenado a la empresa SAINT JULIEN S.A. el retiro del mercado de la fragancia cosmética infantil denominada "AGUA DE AZAHAR marca PETIT ENFANT” Lote N° 27676 luego de detectarse un desvío de calidad relacionado con la presencia de partículas en suspensión.
Por lo antes establecido, se recomienda a quienes hayan adquirido el producto mencionado o lo tenga en su poder, se abstenga de usarlo y realizar la denuncia pertinente en el caso de encontrarlos a la venta en algún comercio para proceder a su respectivo decomiso.
Agradecimiento del grupo de trabajo y familiares participantes de "La soñada"
[23-08-2021] Días pasados, el presidente municipal Dr. Carlos Weiss, recibió en su despacho una nota de agradecimiento de la asociación simple sin fines de lucro “La Soñada”.
En el escrito, el grupo de trabajo y familias que participan de dicha Asociación expresan su gratitud por el envío de maquinaria y tierra para arreglar el camino de acceso al predio donde realizan las actividades semanalmente permitiéndoles a las personas con discapacidad y familiares que los acompañan ingresar sin inconvenientes.
Agradecimiento de la Escuela Agrotécnica Nº73 “Alas Argentinas”
[24-08-2021] Días pasados el Presidente municipal Dr. Carlos Weiss recibió en su despacho una nota de agradecimiento de la Escuela Agrotécnica Nº73 “Alas Argentinas”.
En el escrito, la rectora de la institución, Prof. Sandra Acedo, expresa su gratitud por la donación de bancos de madera que fueron instalados en los entornos formativos pedagógicos, convirtiéndose en un aula abierta para el dictado de clases y anuncia que la comunidad educativa valora significativamente la visita junto a parte del personal de Gabinete la cual permitió dialogar y dar a conocer la oferta formativa de la institución a la que asisten adolescentes y jóvenes de Viale.
Resumen sesión ordinaria Nº 09/21 Honorable Concejo Deliberante
[23-08-2021] Durante la noche del miércoles 18 de agosto, se llevó a cabo la Sesión Ordinaria Nº09/21 del Honorable Concejo Deliberante.
A continuación se detallan los expedientes y proyectos tratados durante la jornada:
Se aprobaron:
- Expte: 6736)Proyecto de Ordenanza sobre creación del “Domicilio electrónico”.
- Expte: 6739) Nota de particular solicitando escrituración de un inmueble.
- Expte: 6744) Proyecto de Resolución declarando de “Interés Social y Cultural” la labor del artista local Nahuel BORRA.
- Expte: 6748) Proyecto de Resolución sobre reconocimiento y declaración de Interés Municipal a la labor del personal de salud de nuestra localidad: Hospital “Dr. Castilla Mira” y Centro de Salud “Ramón Carrillo”.
- Expte: 6751) Proyecto de Ordenanza adhiriendo al programa Nacional “Red de Mentores”.
- Expte: 6754) Proyecto de Resolución declarando de Interés Social y Cultural el Libro “Resurrección de las Campanas” de un conocido y destacado escritor de nuestra Provincia.
- Expte: 6755) Proyecto de Resoluciónde repudiando declaraciones de un funcionario.
- Expte: 6756) Proyecto de Resolución declarando de Interés Social y Cultural el programa radial “Caminata Sabatina”.
- Expte: 6758) Proyecto de Ordenanza sobre adhesión a la normativa Provincial relativa a la reestructuración de pasivos originados en empréstitos tomados.
- Expte: 6762) Nota del D.E.M., adjuntando el Decreto-D.E.M Nº 416/21 sobre aumento de haberes al personal Municipal (8.-%) a partir del mes de julio, incremento del Sueldo mínimo garantizado y demás cuestiones afines.
- Expte: 6764) Proyecto de Ordenanza sobre adhesión a la Ley Provincial Nº 9891 vinculada al desarrollo integral de las personas con discapacidad.
- Expte: 6773) Nota del D.E.M., adjuntando el Decreto-D.E.M Nº 441/21 sobre ingreso de fondos del Ministerio de Desarrollo de Entre Ríos haciendo un aporte de $188.121,30 para la adquisición de un monocultivador destinado al Parque Hortícola Municipal.
- Expte: 6774) Nota del D.E.M., adjuntando el Decreto-D.E.M Nº 442/21 sobre aumento de haberes al personal Municipal y salario mínimo garantizado.
Se pasaron a comisión:
- Expte: 6763) Proyecto de Resolución declarando de Interés Municipal a Libros de autoría del Sr. Humberto FOSSATI.
- Expte: 6766) Proyecto de Ordenanza sobre reglamentación del arbolado público.
- Expte: 6767) Proyecto de Ordenanza sobre creación en la órbita Municipal del área “discapacidad”.
- Expte: 6769) Proyecto de Ordenanza sobre digitalización de proyectos, convocatoria y demás temas afines.
- Expte: 6770) Proyecto de Resolución solicitando colocación de reductor de velocidad sobre Avda. “Pte. Alfonsín” antes de la intersección con Calle “Panutto”.
- Expte: 6771) Proyecto de Resolución solicitando colocación de reductor de velocidad sobre Calle “Ramírez” en lugar a determinar.
- Expte: 6772) Nota de particular solicitando se escriture a su nombre un inmueble.
Se archivó:
- Expte: 6768) Nota del D.E.M., contestando Pedido de Informe sobre préstamo de rodados Municipales a la Junta de Gobierno de “Aldea EIGENFELD”.
¡Alerta! la ANMAT prohibió un aceite de girasol considerado “ilegal”
[23-08-2021] El Área de Bromatología, Ambiente y Zoonosis alerta a los comercios y población en general que la Administración Nacional de Medicamentos, Alimentos y Tecnología Médica prohibió la elaboración, fraccionamiento y comercialización en todo el territorio nacional del producto: “Aceite de Girasol, marca Los Nietos, Contenido Neto 4.5 litros, RNE E/T 3104-28438/16, RNPA E/T 3104-28438/16”.
Según se indica, la prohibición se ha llevado adelante por carecer de autorización de establecimiento y de producto, y estar falsamente rotulado al consignar en su rotulo números de registro inexistentes, resultando ser un producto en consecuencia ilegal.
Por lo antes establecido, se recomienda a quienes hayan adquirido el producto mencionado o lo tenga en su poder, se abstenga de usarlo y realizar la denuncia pertinente en el caso de encontrarlos a la venta en algún comercio para proceder a su respectivo decomiso.
Segunda jornada de capacitación sobre manipulación de alimentos
[20-08-2021] Tal como estaba programado y bajo los protocolos establecidos, esta mañana se realizó una nueva capacitación en manipulación de alimentos en el salón de usos múltiples de la Caja de Jubilaciones y Pensiones del Municipio organizada desde el área de Bromatología, Zoonosis y Ambiente.
Dicha jornada estuvo a cargo del coordinador del área, Médico Veterinario Nerio Badaracco y personal a su cargo donde se remarcó que las buenas prácticas de manufactura son los procedimientos necesarios para lograr un alimento seguro para consumo, ya que nos permiten evitar los riesgos de contaminación, prevención de enfermedades transmitidas por alimentos y pérdidas económicas siendo fundamental aplicarlas en todos los eslabones de la cadena agroalimentaria.
Al finalizar la formación, los participantes ya con los contenidos y herramientas sobre higiene y las buenas prácticas alimentarias realizaron la evaluación correspondiente para la obtención del Carnet de Manipuladores que es emitido por el Instituto de Control de la Alimentación y Bromatología (ICAB) organismo provincial que tiene por objetivo principal resguardar la seguridad alimentaria en todas sus facetas, siendo depositario del cumplimiento del Código Alimentario Argentino al cual nuestra provincia adhiere.
Desde el Área se informa que el próximo grupo ya confirmado realizará su capacitación el próximo viernes, 3 de septiembre en el mismo horario y lugar que las jornadas anteriores con los participantes que reciban su confirmación en tanto aquellos que todavía no se han inscripto, podrán hacerlo en mesa de entrada del Municipio de lunes a viernes de 6:30 a 12:00 horas o en el NIDO de 6:30 a 12:00 y por la tarde de 15:30 a 19:30 horas.
Recorremos la historia y el edificio de la Iglesia Católica - Parroquia Santa Ana de Viale
[20-08-2021] En conmemoración por los 115 años de nuestra localidad, el presidente municipal Dr. Carlos Weiss acompañado por el secretario de Gobierno Prof. Enzo Heft la secrearia de Promoción Social, DG. María Esther Gambelín y la coordinadora de la subsecretaría de Cultura y Educación, Prof. Florencia Landra recorrieron las diferentes comunidades religiosas de nuestra localidad y dialogaron con sus autoridades eclesiásticas y feligreses a los fines de conocer sobre su historia desde sus inicios en Viale, sus edificios y quienes fueron sus primeros miembros.
Las múltiples comunidades religiosas que habitan nuestro país y la región, han sido fundamentales en la construcción cultural e identitaria de nuestra sociedad. En sus diferencias, divergencias y puntos de encuentro se explican elementos fundamentales de los lazos solidarios de nuestro pueblo y del diálogo democrático esencial para la consolidación del sistema de convivencia justo e igualitario.
En nuestra ciudad, cada religión y su comunidad ha tenido un papel fundamental, siendo partícipes en la construcción de la localidad y caminando juntos desde los inicios de la misma.
A continuación se dará a conocer información de la Iglesia Católica - Parroquia Santa Ana:
Desde 1908 la parroquia de Crespo visitaba a los pobladores de la zona pero oficialmente recién en 1922 el padre Vicente Weninges realizó los primeros encuentros en la Cooperativa Centenario, en inmediaciones al paso a nivel de Av. San Martin. También se realizaron las primeras confirmaciones en los galpones de don Aurelio Blas Croce con la presencia del obispo de Paraná Monseñor de Carlo.
Luego de haberse materializado la donación del terreno el 30 de diciembre de 1921 entre la señora Julia del Carril y el Arzobispado de Paraná, se le informa al obispo diocesano Monseñor Abel Bazán y Bustos, que con fecha de 4 de octubre de 1922 fue colocada la piedra fundamental de la futura iglesia donde actuaron como testigos de tal ceremonia Aurelio Blas Croce y Mateo Bruno junto a sus esposas.
La mayoría de los habitantes de la zona eran inmigrantes provenientes de Sambuco, provincia de Cuneo al norte de Italia donde justamente la patrona era Santa Ana por tal motivo se cree que esta fue la advocación elegida para la futura construcción. En 1924 se inicia la excavación de los cimientos realizados por don Juan Vidoz, que junto a Rodolfo Cargnel concluyeron la obra que consistía en un salón y dos habitaciones laterales en el extremo sur. La imagen de Santa Ana fue traída desde Italia y ubicada en el altar mayor, que junto a los altares del Calvario y del Sagrado Corazón ubicados a los laterales fueron donados por las familias de Catalina de Trocello y Rosa de Gieco.
El 14 de julio de 1925 Monseñor de Carlo bendice la ya culminada Iglesia Católica de Viale y días después el 26 de Julio de ese año se celebra la primera fiesta patronal.
El padre Enrique Moeller que venía desde María Grande era el encargado de dirigir las iglesias de Viale, Cerrito y Seguí, estas dos últimas llevaban como patrona a la señora de la Merced por tal motivo Moeller pretendía que Viale también tuviera como patrona a dicha Virgen hecho que no ocurrió y provoco cierto resentimiento de su parte, quien se trasladó a Seguí y se llevó consigo candelabros, manteles de los altares, además del libro de Bautismos de la Capellanía de Viale, que contaba con los registros de nacimientos desde el 1922. Ese libro permaneció retenido 63 años en Seguí, siendo rescatado por el padre Julio Schroeder en 1988. Por este episodio la Capellanía de Viale quedó suspendida hasta el 12 de abril de 1932 cuando es nombrado el Padre Teodoro Hassel como primer sacerdote estable.
El 26 de julio de 1937 fue bendecida la piedra fundamental del futuro colegio de las monjas bajo la advocación de Santa Teresita del Niño Jesús.
En 1944 asume el padre José Lavini, autor del himno a Santa Ana cuya letra perteneció a José Arévalo. También fue el encargado de inaugurar la gruta nuestra Sra. de Lourdes, que había sido donada por el Dr. Juan Castilla Mira, el 29 de septiembre de 1945.
El 9 de febrero de 1953 ingresa como sacerdote Américo Pezzarini, quien impulsó diferentes obras como la inauguración del colegio parroquial en 1957, con el nombre de José Manuel Estrada. El 26 de Julio de 1958 se ampliaba el salón original del templo y se inauguraba la torre y el reloj que fueron donados por el señor Ángel Lovera.
El 6 de julio de 1958 la Capellanía Viale es elevada de rango a Parroquia quedando como el primer párroco de Viale Américo Pezzarini.
El 6 de mayo de 1960 Miguel Ángel Schroeder asume como sacerdote de la iglesia, durante su gestión se inaugura la casa de la Hermanas del Calvario y las primeras aulas del colegio.
Desde el 6 de marzo de 1966 ingresa el Padre Luis Kaul que se destacó por las fiestas patronales masivas y la realización de la casa pastoral, el cielorraso y el cambio de piso del templo, junto a veredas externas.
En Agosto de 1985 ingresa como sacerdote Julio Schroeder que junto al grupo juvenil se encargan de darle forma al Salón Parroquial Don Bosco de amplias dimensiones, y promueve la formación del grupo Scouts Santa Ana.
Desde 1993 y por 24 años de manera ininterrumpida, gracias a un grupo de colaboradores encabezado por Joaquín Sione, se realiza la Fiesta del Agricultor cuyos fondos eran destinados en su totalidad al mantenimiento de la parroquia.
Desde 1994 se suceden varios sacerdotes que continuaron con la obra de la iglesia entre los que podemos nombrar a Cesar Schmidt, Humberto Santiago Pérez, Alberto AbeIdaño, Leonardo Legrass, Ricardo Abalde, Rodrigo Zabala, Juan Carlos Wendler, José María Bustamante.
A partir del año 2007 es nombrado el sacerdote Sergio Hayy quien junto al grupo de mantenimiento continúa con la realización de obras como el revoque completo de los dos laterales externos, calefacción y renovación del sonido del templo. Se realizan Vía Crucis viviente con una muy buena convocatoria de jóvenes y adultos. Se impulsa también actividades solidarias de los jóvenes misioneros.
A partir del año 2016 asume como sacerdote Walter Fattor quien permanece en dicho cargo hasta la actualidad.
Las misas se celebran los días domingos 17:30 y 19:00 horas, y el resto de la semana se llevan adelante en el horario de las 19:00.
Desde el Municipio agradecemos el recibimiento en cada iglesia y la predisposición de sus integrantes para poder compartir con los vecinos, sus creencias que hoy conforman el panorama religioso de nuestra Viale.